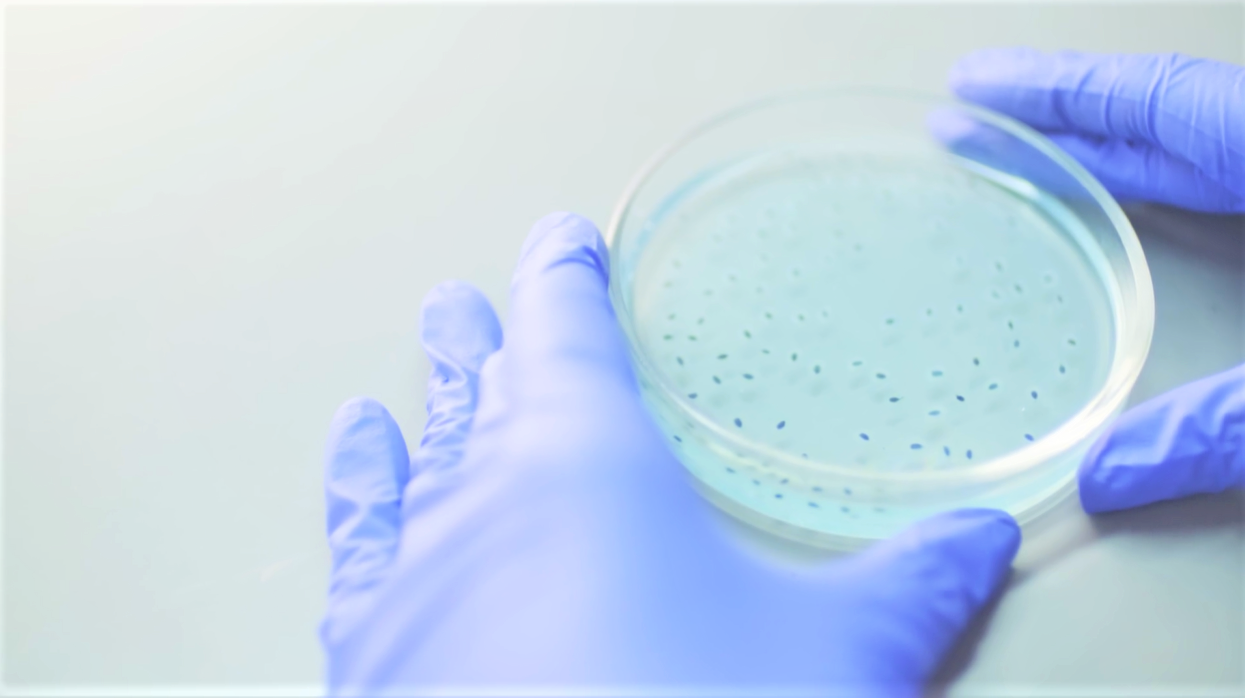
Cell Culture Laboratory Consumables

Cell Culture Laboratory Consumables
Cell culture refers to the process of growing and maintaining cells in artificial conditions in a laboratory setting. This process is essential for a variety of scientific and medical applications, from research on disease mechanisms to drug development and tissue engineering.
In cell culture, cells are kept in a sterile environment under controlled conditions, and provided with nutrients and growth factors necessary for their survival and proliferation. Cell cultures can be derived from various sources, including animal tissues, primary cells, and cell lines. The use of cell culture has revolutionized biomedical research in recent decades, enabling scientists to study complex cellular processes and develop new treatments for diseases.

As a professional manufacturer for critical consumables in laboratory, Yikang Med supply different wells of cell culture plates and dishes. Such as 6 cell culture well plates, 384 deep well plate, 12 cell culture treated plates, culture dishes, etc. All products are made of high-quality materials to ensure sterility, non-toxicity and compliance with international standards. We also provide customized services, such as custom filter tips, to meet customers' special needs.
With advanced production equipment and strict quality control system, our products enjoy a good reputation in the market. Choose us to help your scientific research work more efficient and reliable!
 English
English  中文
中文  日本語
日本語  한국어
한국어  français
français  Deutsch
Deutsch  Español
Español  italiano
italiano  русский
русский  português
português  العربية
العربية  tiếng việt
tiếng việt 





